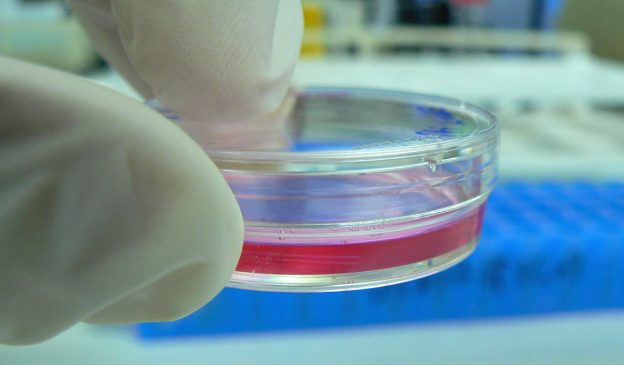

Your Horse Is Not a Therapist
(But They Are Good Medicine)
This and other notes on horses and depression

When I teach horse riding to friends and family, I use like and as like trailer hitches: they pull my students into different concepts while they are in the saddle.
“Hold the reins like a baby bird.”
“Imagine the horse as a river, and your legs as the banks guiding the river along.”
“I want you to push down through your heels like you could break the stirrups.”
Unlike riding, the metaphors I use for depression never describe it with much accuracy. Depression is at once an absence of things and a too much of things, a void, a slowing down, a speeding up, it’s too much and too little.
Instead, my depressive episodes are blotted, memories. They are moments half-vacant. The first time I remember having symptoms, all I could pull up from the database of my memory was the hum of my parents’ air conditioner at eleven in the morning. It was gurgling. Droning thuds right outside the door where I slept. It was the summer of 2008, the gas prices rose, the economy crumbled, and the coda of my existence was staying in bed because there was no point in getting out of it.
It went away when I went back to school the following autumn. Or, at least, I thought it did. I can still hear the echoes of school friends, telling me that maybe there was more to my melancholy than just sadness and being a chronic overachiever.
I ignored them.
After college, I lived on a horse farm in rural Colorado. It had a million-dollar view of slotted canyons and farm fields stretching for miles. Most days I rolled out of bed by 7:00am, fed 20 horses, cleaned out their runs for the day, did chores, and then wrote website copy for a marketing agency in a little office that faced east.
I remember the raccoons squabbling over the dumpster at night, the echo of coyotes after a kill, and the thrill of a shooting star streaking the sky with luminous urgency. I loved riding just before sunset, watching the red dust cast clouds behind the horses hooves. I can also remember waves of nauseating numb and a strange sense of dread that never really lifted. Some days didn’t pass, they army-crawled.
The rhythm of farm life masked my symptoms. I have what doctors call “high functioning” clinical depression: it never mattered how crappy I felt or how existential I got or how much of a mess my relationships became, horses still needed to be fed, water troughs cleaned, and manure cleared away. Cowgirls don’t cry.
I DIDN’T UNDERSTAND THAT I WAS SICK.
Now almost five years since I first lived on that farm, I know that I can do most basic things when I am depressed. I can go to the grocery store, pay bills and answer the phone. I am one of the lucky ones.
What I can’t do is notice details. I can’t write, stay organized, or meet deadlines. I stop being able to pick up after myself or see anything as worthwhile. I eat too much or too little; sleep becomes a curse and a blessing. Before I knew I had depression, I would just blame my lack of self-discipline. I thought it was my dyslexia, a character flaw, or maybe I just wasn’t getting enough sleep. I told myself I needed to get up earlier, eat better, or drink more coffee. I didn’t understand that I was sick.
It is very unlikely I could have known I had depression. I had no idea what depression was.
My understanding of mental illness came from one high school production of David and Lisa and two 100 level psychology courses that still presented mental illness as uncommon. I thought anxiety was a normal state of being and depression was just bouncing, egg-shaped heads that smiled and talked about sexual side effects in Zoloft commercials.
Besides, I got to spend a lot of time with horses; my beliefs told me that if I had everything I wanted there was just no way I could be depressed. But that was exactly what was happening.
Depression or major depressive disorder as defined by the American Psychiatric Association is “a common and serious medical illness that negatively affects how you feel, the way you think and how you act.” Common symptoms include lack of energy, becoming withdrawn and numb to your environment, a sense of dread, despair, guilt, or worthlessness. It is also common for depressives to isolate themselves and stop doing the things they care about. It can impact sleeping and eating patterns and can show a drastic shift in behavior and personality. While these are the most common symptoms, each case varies from person to person, episode to episode.
For us farm folk of the world, this may seem flowery and self-involved. Me, a few years ago would have said, “Oh how sad for you, now get up and get stuff done.”
No matter my shame and judgment, the dollar signs in front of depression are staggering and very, very real. A 2015 study showed depression cost the United States $210 billion every year, this accounts for everything from lost wages, to treatment and other direct and indirect costs and losses. If it was a fake disease like I once believed it was, shouldn’t it be cheaper?
If the cost in dollars and cents weren’t enough to leave us blushing over the manure pile, the number of people with the disease should do the trick. The National Alliance on Mental Illness reports that more that 43.8 million Americans suffered from some form of mental illness in 2015. This is just under one in five Americans.
Depression, which is the most common mood disorder, is also recognized by the Center for Disease Control as “a serious medical illness and an important public health issue.” Thus while we would all love to say, that depression and other mental illness never enters into the barn, the facts are stacked against us.
There is a t-shirt in many horse catalogs that says “My horse is my therapist.” I once would have purchased it in a couple of different colors. Now, as the resident Captain Killjoy of the barn, I want to say, “Cool, maybe they’ll make ‘My horse is my Chemotherapy,’ or how about this potential best-seller ‘My horse is my fast-acting inhaler.’”
If you just found the second two offensive, then yes, the first one is too. The reason it is problematic is not because our time with horses isn’t therapeutic. But rather because it diminishes mental illness as a lesser, illegitimate disease.
I, too, fell for the ethos of the horse as a cure-all for mental illness. I once thought therapy and psychiatric medication was for bored, wealthy people and the occasional hypochondriac. I also thought it was only effective for those with really low functioning diagnoses and meth addicts.
I WAS A FARM GIRL, STRANGERS TOLD ME I SEEMED TOUGH. WHO WAS I IF I LOST THAT?
On the other hand, I was also terrified. My imagination told me that if I went to a therapist, I’d be institutionalized like I had seen in the movies or I’d be the one thing I had convinced myself I was not: weak.
I was a horse person; I was a farm girl, strangers told me I seemed tough. Who was I if I lost that?
I would never think I was weak if I went to the emergency room because I got chucked off a horse and landed badly. I also wouldn’t think I was weak if I went to a doctor because I caught pneumonia after breaking the ice out of water buckets. The same logic should have applied to seeking treatment for depression.
Yet, when I talked myself into making an appointment with the mental health department I spent the entire phone call to the doctor in a cold sweat. I also considered running out of the waiting room in a panic before my first consultation had even started. Old stigmas against mental illness are a hard thing to silence, even if that mental illness is slowly trying to kill you.
Treatment turned out to be nothing like I imagined. There was minimal mood lighting, pedantic banter or forced breathing exercises. Therapy and treatment turned out to be very much like taking riding lessons. I paid a therapist for the same reason I paid a riding instructor: to notice things. They used their training and expertise and made me better. Just like a riding instructor had shown me that I had a nasty habit of letting the horse fall in at the corner, a therapist showed me how my emotional patterns were making me sicker. After noting the problem, they then gave me strategies to improve.
IT IS STILL A PART OF MY LIFE, BUT IT NO LONGER CONTROLS MY LIFE.
I know that if I had treated my depression sooner, I would have enjoyed my days on the farm more, I would have ridden more, worked harder, and laughed more. I would have been a better advocate for the horses I rode. If I had started therapy sooner, I would have ridden better, too. I would have spent the time noting reality, instead of simply trying to stay afloat in a soup of depression induced self-deprecation.
I am still not free of depression but because I understand it, I am better at taking care of myself when it appears. It is still a part of my life, it probably always will be, but it no longer controls my life.
You may, at this point, think I have sworn off horses as medicine altogether. If I had struggled that hard with depression when I was around horses every day, you might be surprised to hear that I do believe that horses are a valid way to help treat depression and other mental illnesses.
“Help treat” is the key statement here. My feelings on equine therapy for mental illness simply hold more specific parameters than they once did. I believe that if equine therapy is a primary treatment then it should be done in the company of a trained professional. In fact, this kind of therapy on horseback or in the company of horses is done all over the world and has been used to treat everyone from teens with severe anxiety, to veterans with PTSD, to those incarcerated. While research on the effectiveness of equine-based therapy for mental illness is still in its early stages, early studies show promise.
Time with horses have proven to be one of my best forms of secondary treatment to supplement therapy and medication. One of the beautiful things about depression, notes psychology writer Andrew Solomon, is that it is a disease that impacts the way we feel. If someone has diabetes, lunges a horse, and feels better, they will still leave the round pen with diabetes. If someone goes into a round pen with depression and lunges a horse makes them feel better, then for that moment it is an effective treatment for depression.
Exercise is also often a key component in treating depression and, for many, being around horses is a good excuse for doing just that. It also can provide a low-stress way to cut down on isolation as our interactions with horses can have lower social stakes than those with other people.
I now understand that cowgirls do cry and we should. Our time with horses should be a safe time to struggle and change and talk and perhaps find some relief from what ails us. If it is not, then it’s important to find out the reason why and do what we can to address it.
Asking for help isn’t a sign of weakness, it is a sign of agency and self-awareness and these are two things that I, as a horse person, have learned to admire.
Even if I can’t use metaphors to describe depression, I can use one to describe what it is like when it lifts. When the depression first lifts, it feels like the first time I correctly rode a flying lead change. There is a moment of flight, of release, of understanding and clarity that is so delicious I wish I could bottle it and keep it on a windowsill. It’s as if the mysterious thing that I had been prevented from understanding is now understood.
When depression is gone, I can see the steam curl from a sweaty horse in the morning light with a renewed sense of wonder. I can laugh at horse galloping at play in a pasture.
When my depression lifts, it is as though I can pull myself out of the dingy trailer of my despair and a long trail ride awaits, and my horse is already saddled.
About the Author
Gretchen Lida is an essayist and equestrian. Her work has appeared in Brevity, Earth Island Journal, Washington Independent Review of Books, and many others. She has an MFA in Creative Nonfiction from Columbia College Chicago and currently lives in Wisconsin. Follow her on Twitter at @GC_Lida.